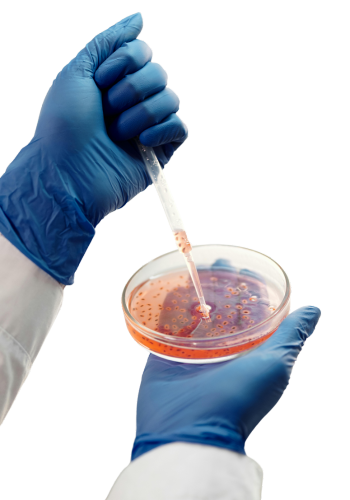

Advertisement
Psoriasis
Clinical Research Areas
Explore our diverse Clinical Research Areas, where we drive medical advancements across multiple specialties. We are dedicated to clinical research in key areas to improve the health and well-being of individuals. Through our clinical studies, we seek innovative solutions for the most relevant health challenges. Currently, we are conducting studies in: Asthma, COPD (Chronic Obstructive Pulmonary Disease), RSV (Respiratory Syncytial Virus), Psoriasis, Atopic Dermatitis, Onychomycosis, Contraceptives, Postmenopausal, Cardiovascular Diseases, Osteoarthritis, Chronic Lower Back Pain, Type II Diabetes Mellitus, Vasomotor Symptoms, and Cytomegalovirus.
Our Expert Team
Partner with a team that understands the critical importance of robust clinical data for regulatory success. Our expert team offers strategic guidance and meticulous execution of your research protocols, providing the expertise you need to confidently navigate the path to medical treatment approval.

Dr. Gilberto Jiménez
Principal Investigator
gjimenez@intldermresearch.com

Ariel Sotolongo (APRN) Dermatology
Sub- investigator